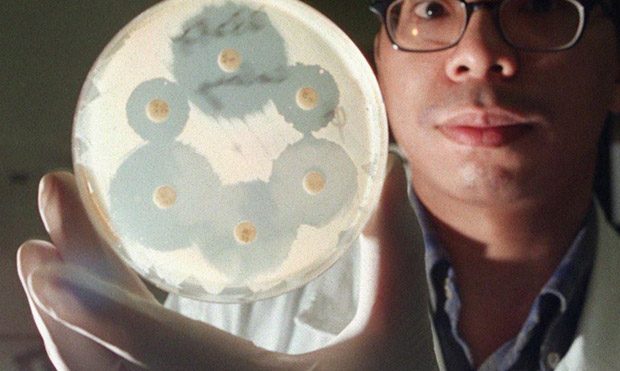

توریست مالزی
۱۸ آبان ۱۳۹۷
توریست مالزی – سازمان همکاری و توسعه اقتصادی (OECD) روز چهارشنبه گفت عفونتهای ناشی از «ابر باکتری ها» که هر سال جان میلیونها نفر را در سراسر جهان می گیرد می توان با هزینه کردن دو دلار برای هر نفر در سال متوقف کرد.
به گزارش خبرگزاری رویترز این نهاد باکتریهای مقام در برابر دارو را «یکی از بزرگترین خطرهای موجود برای پزشکی» توصیف کرده و افزود اگر اقدامات لازم انجام نشود «ابرباکتری»ها طی ۳۰ سال آینده فقط در اروپا، استرالیا و آفریقا موجب مرگ حدود ۲.۴ میلیون نفر خواهند شد.
علم پزشکی از سال ۱۹۲۸ که پنی سیلین، اولین داروی آنتی بیوتیک، کشف شد با مشکل عفونت ناشی از باکتری هایی که در برابر دارو مقاوم می شوند روبرو بوده است. در سالهای اخیر به دلیل افزایش تعداد باکتریهای مقام در برابر داروها و کاهش سرمایه گذاری شرکتهای داروسازی در این زمینه این مشکل افزایش یافته است.
سازمان بهداشت جهانی هشدار داده اگر اقدامات جدی انجام نشود در قرن میلادی حاضر دوران پسا آنتی بیوتیک، که خدمات درمانی اساسی به دلیل عفونت در جراحیهای ساده ممکن است جان بیماران را به خطر بیاندازد، از راه خواهد رسید.
پژوهشی که در سال ۲۰۱۴ با حمایت دولت بریتانیا انجام شد هشدار داد اگر این مشکل کنترل نشود تا سال ۲۰۵۰ ممکن است هر سال ۱۰ میلیون نفر دیگر جان خود را از دست داده و هزینهای تا ۱۰۰ تریلیون دلار به نظام پزشکی جهانی تحمیل شد.
سازمان همکاری و توسعه اقتصادی در گزارش خود می گوید:«سرمایه گذاری کوتاه مدت برای کنترل این مشکل جان بسیاری را نجات داده و هزینههای پزشکی را کاهش خواهد داد.»
در این گزارش پنج روش مقابله با باکتریهای مقاوم در برابر داروها پیشنهاد می شود از جمله بهبود بهداشت شخصی، متوقف کردن تجویز بیش از حد آنتی بیوتیک ها، آزمایش سریع بیماران برای تشخیص مناسبترین دارو برای عفونت، به تاخیر انداختن تجویز آنتی بیوتیک و کارزارهای آگاهگرانه در رسانه ها.
خبرگزاری رویترز می افزاید در این گزارش حدی از خوش بینی محتاطانه نیز وجود دارد و بعنوان مثال نرخ متوسط افزایش مقاومت باکتریها حداقل در کشورهای عضو سازمان همکاری و توسعه اقتصادی تا حدی رو به کاهش است. ولی در عین حال این گزارش تاکید می کند که « جای نگرانی شدیدی وجود دارد.»
پیش بینی می شود که در کشورهای عضو این سازمان میزان مقاومت در برابر آنتی بیوتیکهای ردیف دوم و سوم که داروهای بسیار قوی و آخرین عامل دفاعی در برابر عفونت هستند تا سال ۲۰۳۰ به نسبت سال ۲۰۰۵ حدود ۷۰ درصد افزایش یابد.
در عین حال پژوهشها نشان می دهند که مقاومت در برابر داروها در کشورهای با درآمد اندک و متوسط به سرعت افزایش خواهد یافت. به عنوان مثال در برزیل، اندونزی و روسیه بین ۴۰ تا ۶۰ درصد از موارد عفونت ناشی از مقاومت باکتریها در برابر دارو است. ولی این رقم در میان کشورهای سازمان همکاری و توسعه اقتصادی بطور متوسط حدود ۱۷ درصد است.
در عین حال پیش بینی می شود که افزایش مقاومت باکتریها در برابر دارو در کشورهای فقیر و متوسط تا سال ۲۰۵۰ چهار تا هفت برابر این میزان در کشورهای عضو این سازمان خواهد بود.
تیم جینکس کارشناس مقاومت در برابر دارو گفت:«گزارش سازمان همکاری و توسعه اقتصادی نشان می دهد که با روشهای ساده کنترل و پیشگیری می توان جان بسیاری را نجات داد . ابر باکتریها برای بهداشت و توسعه جهانی یک خطر جدی هستند و سرمایه گذاری برای مقابله با آنها علاوه بر نجات جان مردم می تواند از هزینههای مالی سرسام آور در آینده پیشگیری کند.»
منبع: رادیو فردا
به گزارش خبرگزاری رویترز این نهاد باکتریهای مقام در برابر دارو را «یکی از بزرگترین خطرهای موجود برای پزشکی» توصیف کرده و افزود اگر اقدامات لازم انجام نشود «ابرباکتری»ها طی ۳۰ سال آینده فقط در اروپا، استرالیا و آفریقا موجب مرگ حدود ۲.۴ میلیون نفر خواهند شد.
علم پزشکی از سال ۱۹۲۸ که پنی سیلین، اولین داروی آنتی بیوتیک، کشف شد با مشکل عفونت ناشی از باکتری هایی که در برابر دارو مقاوم می شوند روبرو بوده است. در سالهای اخیر به دلیل افزایش تعداد باکتریهای مقام در برابر داروها و کاهش سرمایه گذاری شرکتهای داروسازی در این زمینه این مشکل افزایش یافته است.
سازمان بهداشت جهانی هشدار داده اگر اقدامات جدی انجام نشود در قرن میلادی حاضر دوران پسا آنتی بیوتیک، که خدمات درمانی اساسی به دلیل عفونت در جراحیهای ساده ممکن است جان بیماران را به خطر بیاندازد، از راه خواهد رسید.
پژوهشی که در سال ۲۰۱۴ با حمایت دولت بریتانیا انجام شد هشدار داد اگر این مشکل کنترل نشود تا سال ۲۰۵۰ ممکن است هر سال ۱۰ میلیون نفر دیگر جان خود را از دست داده و هزینهای تا ۱۰۰ تریلیون دلار به نظام پزشکی جهانی تحمیل شد.
سازمان همکاری و توسعه اقتصادی در گزارش خود می گوید:«سرمایه گذاری کوتاه مدت برای کنترل این مشکل جان بسیاری را نجات داده و هزینههای پزشکی را کاهش خواهد داد.»
در این گزارش پنج روش مقابله با باکتریهای مقاوم در برابر داروها پیشنهاد می شود از جمله بهبود بهداشت شخصی، متوقف کردن تجویز بیش از حد آنتی بیوتیک ها، آزمایش سریع بیماران برای تشخیص مناسبترین دارو برای عفونت، به تاخیر انداختن تجویز آنتی بیوتیک و کارزارهای آگاهگرانه در رسانه ها.
خبرگزاری رویترز می افزاید در این گزارش حدی از خوش بینی محتاطانه نیز وجود دارد و بعنوان مثال نرخ متوسط افزایش مقاومت باکتریها حداقل در کشورهای عضو سازمان همکاری و توسعه اقتصادی تا حدی رو به کاهش است. ولی در عین حال این گزارش تاکید می کند که « جای نگرانی شدیدی وجود دارد.»
پیش بینی می شود که در کشورهای عضو این سازمان میزان مقاومت در برابر آنتی بیوتیکهای ردیف دوم و سوم که داروهای بسیار قوی و آخرین عامل دفاعی در برابر عفونت هستند تا سال ۲۰۳۰ به نسبت سال ۲۰۰۵ حدود ۷۰ درصد افزایش یابد.
در عین حال پژوهشها نشان می دهند که مقاومت در برابر داروها در کشورهای با درآمد اندک و متوسط به سرعت افزایش خواهد یافت. به عنوان مثال در برزیل، اندونزی و روسیه بین ۴۰ تا ۶۰ درصد از موارد عفونت ناشی از مقاومت باکتریها در برابر دارو است. ولی این رقم در میان کشورهای سازمان همکاری و توسعه اقتصادی بطور متوسط حدود ۱۷ درصد است.
در عین حال پیش بینی می شود که افزایش مقاومت باکتریها در برابر دارو در کشورهای فقیر و متوسط تا سال ۲۰۵۰ چهار تا هفت برابر این میزان در کشورهای عضو این سازمان خواهد بود.
تیم جینکس کارشناس مقاومت در برابر دارو گفت:«گزارش سازمان همکاری و توسعه اقتصادی نشان می دهد که با روشهای ساده کنترل و پیشگیری می توان جان بسیاری را نجات داد . ابر باکتریها برای بهداشت و توسعه جهانی یک خطر جدی هستند و سرمایه گذاری برای مقابله با آنها علاوه بر نجات جان مردم می تواند از هزینههای مالی سرسام آور در آینده پیشگیری کند.»
منبع: رادیو فردا